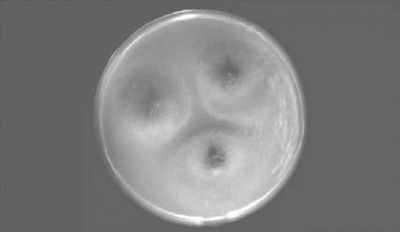
Леонид Рудницкий - Плесень - лекарство или яд?

Рис. 5. Споры плесени под микроскопом
Плесень – убийца младенцев
Загадочные смерти нескольких младенцев в Огайо привлекли внимание к этому месту всей мировой общественности. Именно тогда грибок Стакиботрис атра (Stachybotrys atra) был высеян из легких семилетнего мальчика. После серьезных исследований было выяснено, что этот вид плесени может вызвать серьезные проблемы со здоровьем. Вырастая дома, Stachybotrys atra превращается в коварного врага, который очень быстро способен расправиться с самыми слабыми жителями планеты. Грибок Stachybotrys atra выбрасывает ядовитые споры, которые легко вдыхаются. На открытом воздухе они сравнительно быстро разрушаются, но во влажном, плохо проветриваемом помещении, на отопительных трубах или на обоях плесень быстро разрастается. В доме, где обнаружили грибок, дети страдали от мигреней, кашля, у них слезились глаза, они чувствовали себя постоянно уставшими и изможденными, что заставляло их родителей часто обращаться к педиатру. У матери открылась гормонозависимая астма. Врачи никак не могли обнаружить причину недомоганий, хотя было очевидно, что причина у всех болеющих была общей. Однако никого из членов семьи не догадались проверить на грибок. Лишь ветеринар, лечивший их шотландского колли Рокки, страдавшего от рвоты и диареи, сделал псу необходимые анализы. У него был обнаружен грибок, поселившийся в желудочно-кишечном тракте. Позднее ученые университета Case Western Reserve (Кливленд, США) обнаружили связь между Stachybotrys atra и необычным уровнем смертности младенцев от легочных кровотечений. Десять младенцев, умерших по этой причине, жили в плохих домах с поврежденным водопроводом в Кливленде, причем все здания были сгруппированы на одной территории. С тех пор в США зарегистрировано уже 160 таких случаев.
Проклятие фараонов
При сенсационной находке мумии Тутанхамона в короткое время умерли двадцать два человека. Их было семнадцать человек, следом за Картером и Карнарвоном шагнувших 13 февраля 1923 года в погребальную камеру. Другим довелось исследовать его мумию. Их смерть породила миф о проклятии фараонов, которые мстили за нарушение своего покоя.
Можно определить общие симптомы и диагностику смерти людей, чьи судьбы так или иначе оказались связаны с проклятием фараонов, – эту тему досконально исследовал Филипп Ванденберг, подняв истории болезней, свидетельства очевидцев, биографические заметки из жизни не только современников, но и ученых, еще в прошлом веке имевших дело с гробницами древнеегипетских царей. Вот они – грозные признаки неизбежной трагической развязки: сильнейшая лихорадка, навязчивый бред, предчувствие близкой кончины; эмболия; скоротечный рак.
Минуло тридцать пять лет со смерти Карнарвона, когда Джоффри Дин – врач госпиталя в Порт Элизабет (Южная Африка) – обнаружил, что симптомы болезни, от которой скончался лорд, а следом за ним те, кто ухаживал за больным, весьма напоминают "пещерную болезнь", известную медикам. Ее разносят микроскопические грибки, обитающие в организме животных, чаще всего летучих мышей, в органических отбросах и пыли. А уж чего-чего, а этого добра было предостаточно в фараоновых склепах. Те, кто первым срывал печать, и те, кто шел следом, вдыхали грибки. Болезнь эта заразная: вот почему ухаживавшую за лордом женщину ждала та же участь…
Медик-биолог Каирского университета Эззеддин в течение многих месяцев наблюдал за археологами и сотрудниками музея в Каире и в организме каждого из них обнаружил грибок, провоцирующий лихорадку и сильнейшее воспаление дыхательных путей. Сами грибки представляли собой целое скопище болезнетворных агентов, и среди них – Aspergillus niger, обитающий в мумиях, пирамидах и склепах, тысячелетиями остававшихся закрытыми для всего мира.
Таким образом, причиной смерти лиц, вскрывавших гробницы египетских фараонов, была желтая плесень, выделяющая афлатоксин. Афлатоксин вызывает тяжелые пневмонии и рак печени.
Неутешительные результаты эксперимента
Ученые провели серию экспериментов для изучения возможностей антигрибковых средств. Так, в пробирку с таким средством поместили грибок. Большая часть клеток погибла. Однако лишь часть! Другая, небольшая часть клеток сохранилась. Шансы на выживание у плесени были сходны с шансами на выживание человека, погруженного в серную кислоту. Выживших клеток было достаточно, чтобы в короткий срок вырастить новую колонию. Вывод ученых неутешителен: плесень практически неубиваема.

Рис. 6. Научный эксперимент по уничтожению плесени
Зараженные продукты разрушают печень
Африканское племя банту намеренно хранит продукты таким образом, чтобы они покрывались плесенью – это придает им специфический вкус. Представители этого этноса более всех в мире страдают раком печени, они умирают, не дожив и до 40 лет.
В Индии для развития плесени идеальные условия: там тепло и сыро. Неслучайно в Индии очень высок процент заболевания детей, которых кормили "желтым рисом", циррозом печени. Он весь заражен афлатоксином.
Плесень атаковала американских врачей и медсестер
Американские ученые из Корнельского университета (штат Нью-Йорк) случайно заинтересовались необъяснимыми случаями заболевания врачей, медсестер и посетителей больниц легочным аспергиллезом. То, что вызывает эту болезнь плесень, они не сомневались, но сначала думали, что ее источник – вентиляционные системы. После длительного изучения все-таки установили, что она "нападает" на человека из одежды. Для обитания плесени наиболее подходит хлопковая ткань.
Законы солнечной активности
В 1935 году великий русский ученый Александр Чижевский изучал реакцию микроорганизмов на вспышки солнечной активности. Он выяснил, что с ростом солнечной активности повышается агрессивность плесени.

Рис. 7. Александр Чижевский
Девять раз в столетие, по два-три года каждый, солнечные пертурбации посылают в пространство, образно говоря, осколки атомного и ядерного распада высоких энергий, сильные фотонные и радио излучения. Соответственно каждый раз на протяжении двух-трех лет все явления земной неорганической и органической природы приходят в возбуждение (магнитные и электрические бури, землетрясения, смерчи, наводнения, пожары лесов и т. п.). Активизируются микробы и вирусы, по всем континентам прокатываются эпидемии и пандемии, обостряются хронические заболевания, возрастает общая смертность во всех странах.
Рукописи Леонардо да Винчи – в опасности!
В 2007 году все мировые информагентства с тревогой передали: рукописи великого живописца гибнут. Самую большую коллекцию рисунков и рукописей легендарного Леонардо да Винчи, известную как Кодекс Атлантикус, что хранится в библиотеке Амброзиана в Милане, пожирает плесень.
Бумага из корицы спасает хлеб от плесени
Очень невзлюбили плесень испанцы. Не секрет, что испанские барышни худобой не страдают, а испанские булочки очень вкусны. И вот испанские ученые изобрели новую упаковочную бумагу. Изготавливается она на основе масла корицы и может предохранить от плесени хлебобулочные изделия до десяти дней, сохраняя при этом свежесть хлеба.
Ученые из университета Сарагосы отмечают, что ранее для борьбы с плесенью пытались использовать самые разнообразные методы: облучение ультрафиолетом, стерильную упаковку, различные химикаты. По их мнению, лучшим методом может быть использование "активной упаковки", которая сама "атакует" грибок.
Ученые изготовили несколько вариантов "активной упаковки" из вощеной бумаги, пропитанной коричным маслом в разных концентрациях. Затем они "заразили" некоторыми разновидностями плесневого грибка свежий белый хлеб и оставили его на несколько дней, завернув один кусок в обычную бумагу, а второй – в "активную".
Результаты показали, что упаковка, содержащая лишь 6 % коричного масла, на 96 % подавляет рост плесени. Коричная бумага сохраняла свои антигрибковые свойства более десяти дней.
На основе этого открытия группа тайваньских ученых провела свое исследование и сообщила, что обнаружила у коричного масла также свойства репеллента – по их данным, это вещество даже в небольших количествах эффективно уничтожает москитов.
Колокольный набат – средство спасения
Во время эпидемий тяжелых заболеваний, свирепствовавших в Средние века на Руси, все церкви оглашали воздух тревожным набатом. Он звучал как клич SOS! Современная звуко-анализирующая техника позволила провести исследования, которые показали, что ультразвуковые обертоны колокольного благовеста (с частотой более 25 килогерц) повышают иммунитет и даже подавляют рост патогенных микроорганизмов.

Рис. 8. Целебный звон колоколов